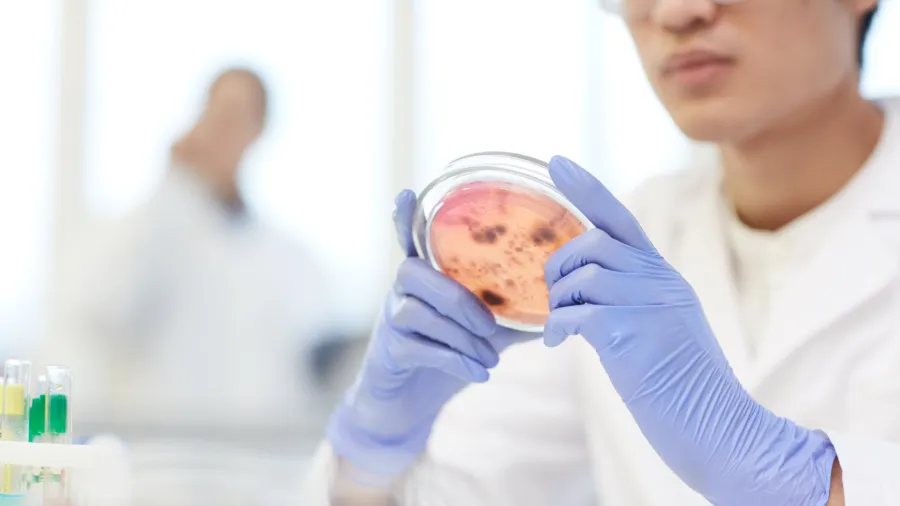

Medical membranes market to be valued at $6.66b by 2030
Growth in drug delivery and tissue regeneration drives market growth.
The medical membranes market is expected to reach $6.66b by 2030 at a compound annual growth rate of 9.1%, said MarketsandMarkets.
The sector’s expansion is attributed to the rising burden of chronic kidney disease, an ageing population, an increase in diabetes cases, and the growing number of end-stage renal disease patients.
Growth in key areas such as drug delivery, tissue regeneration, and sterile filtration, along with the shift to single-use systems to reduce infection risk, is driving the market.
“Membrane material advancements such as polysulfone, polyethersulfone, and mixed-matrix membranes with increased flux and antifouling properties are not only making treatment easier but also leading to better patient outcomes,” the report said.



















 Advertise
Advertise









